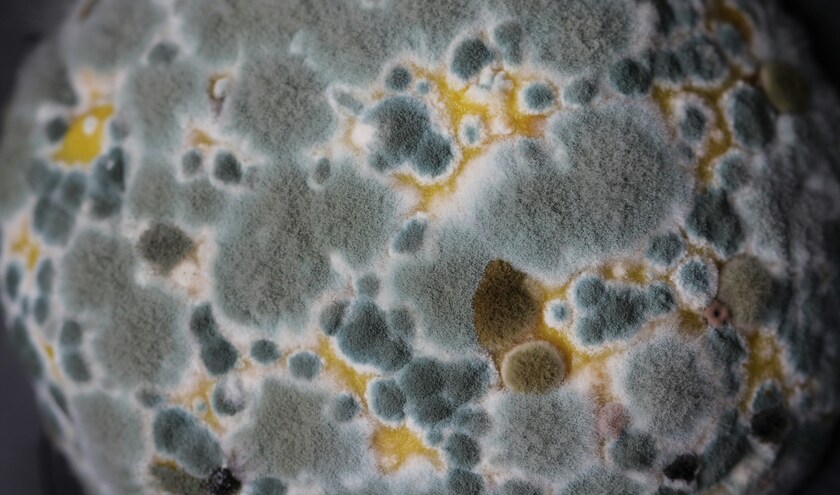
(c) Sandy Millar/Unsplash

The Investigation and Commencement of Repair (Scotland) Regulations 2026 will introduce new duties on landlords to investigate reports of damp and mould and start any repairs needed within a set timescale if approved by Parliament.
Housing secretary Màiri McAllan said: ‘Everyone deserves to live in a home free from damp and mould. These regulations will help to ensure that's the case by requiring any instances to be swiftly investigated by landlords and prompt action taken.
‘In Scotland, while 90% of homes are free from damp and mould, we want to make sure everyone is protected. That's why we are leading the way in rolling out these protections to both social and private tenants. We have worked closely with tenant groups, landlords and other stakeholders to develop regulations that protect tenants while being practical for landlords to implement.
‘We will also be raising awareness of the importance of identifying and addressing damp and mould issues as quickly as possible.'
This is the first set of regulations for the implementation of Awaab's Law, named after two-year-old Awaab Ishak who died in 2020 from a respiratory condition caused by mould in his family's housing association flat in England.